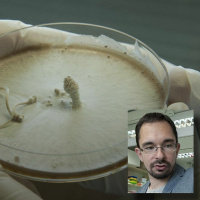
Gombatörténetek - beszélgetés Nagy Lászlóval

Synopsis
Podcast by Magyar Tudományos Akadémia
Episodes
-
Álmodnak-e a digitális bölcsészek ráolvasás-adatbázisokról? - beszélgetés Ilyefalvi Emesével
21/05/2021 Duration: 01h19minHáttérinformációk, olvasnivaló: mta.hu/podcast A nyitószignál forrása: Freesound.org/X3nus – CC-BY 3.0 A lezáró blokk aláfestő zenéjének forrása: Soundcloud/PeriTune – CC-BY 3.0
-
Félreismert csúszómászók, hidegvérű felfedezések - beszélgetés Vörös Judittal
06/04/2021 Duration: 01h15minHáttérinformációk, olvasnivaló: mta.hu/podcast A nyitószignál forrása: Freesound.org/X3nus – CC-BY 3.0 A lezáró blokk aláfestő zenéjének forrása: Soundcloud/PeriTune – CC-BY 3.0
-
Páncélba zárt sokféleség – beszélgetés Merkl Ottóval
09/02/2021 Duration: 01h21minHáttérinformációk, olvasnivaló: mta.hu/podcast A nyitószignál forrása: Freesound.org/X3nus – CC-BY 3.0 A lezáró blokk aláfestő zenéjének forrása: Soundcloud/PeriTune – CC-BY 3.0
-
Emlősök égen-földön (és föld alatt) - beszélgetés Csorba Gáborral
22/01/2021 Duration: 01h45minHáttérinformációk, olvasnivaló: mta.hu/podcast A nyitószignál forrása: Freesound.org/X3nus – CC-BY 3.0 A lezáró blokk aláfestő zenéjének forrása: Soundcloud/PeriTune – CC-BY 3.0
-
Szerethető matematika – beszélgetés Juhász Péterrel
17/07/2020 Duration: 01h52minHáttérinformációk, olvasnivaló: mta.hu/podcast A nyitószignál forrása: Freesound.org/X3nus – CC-BY 3.0 A lezáró blokk aláfestő zenéjének forrása: Soundcloud/PeriTune – CC-BY 3.0
-
Ködpiszkáló füvesember - beszélgetés Csupor Dezsővel
15/05/2020 Duration: 01h17minHáttérinformációk, olvasnivaló: mta.hu/podcast A nyitószignál forrása: Freesound.org/X3nus – CC-BY 3.0 A lezáró blokk aláfestő zenéjének forrása: Soundcloud/PeriTune – CC-BY 3.0
-
Gombatörténetek - beszélgetés Nagy Lászlóval
03/04/2020 Duration: 01h10minHáttérinformációk, olvasnivaló: mta.hu/podcast A nyitószignál forrása: Freesound.org/X3nus – CC-BY 3.0 A lezáró blokk aláfestő zenéjének forrása: Soundcloud/PeriTune – CC-BY 3.0
-
Múltunk kettős spirálja - beszélgetés Mende Balázzsal és Szécsényi-Nagy Annával
28/02/2020 Duration: 01h35minHáttérinformációk, olvasnivaló: mta.hu/podcast A nyitószignál forrása: Freesound.org/X3nus – CC-BY 3.0 A lezáró blokk aláfestő zenéjének forrása: Soundcloud/PeriTune – CC-BY 3.0
-
Sörök, naplók, szerelmek - beszélgetés Katona Csaba történésszel
07/02/2020 Duration: 01h35minHáttérinformációk, jegyzetek az mta.hu/podcast címen A nyitószignál forrása: Freesound.org/X3nus – CC-BY 3.0 A lezáró blokk aláfestő zenéjének forrása: Soundcloud/PeriTune – CC-BY 3.0 A címlapkép hátterének forrása: Fortepan/Schmidt Albin
-
Mennyit ér egy erdő? - beszélgetés Aszalós Rékával
24/01/2020 Duration: 01h07minA klímaváltozás kapcsán egyre elkerülhetetlenebb, hogy feltegyük a kérdést: mennyit ér számunkra valójában az erdő? Gilicze Bálint az Ökológiai Kutatóközpont munkatársával, Aszalós Réka erdőökológussal beszélget az MTA Podcast új adásában amazonasi erdőtüzekről, a faültetési programok esélyeiről és arról, hogy mi mindent nyújthat az embernek az őt körülvevő természeti környezet. További infó: http://mta.hu/podcast/ A nyitószignál forrása: Freesound.org/X3nus – CC-BY 3.0 A lezáró blokk aláfestő zenéjének forrása: Soundcloud/PeriTune – CC-BY 3.0
-
Két atommag, ha egyesül - beszélgetés a fúzióról Szabolics Tamással
02/01/2020 Duration: 54minA nyitószignál forrása: Freesound.org/X3nus – CC-BY 3.0 A lezáró blokk aláfestő zenéjének forrása: Soundcloud/PeriTune – CC-BY 3.0
-
"Csak az a szép zöld gyep..." - beszélgetés Török Péter ökológussal
11/12/2019 Duration: 01h11minMi a különbség a focipályák üde pázsitja és az ökológusok gyepe között? Hogyan vásároljunk okosan fűmagot? Miben térnek el a birkák és a marhák étkezési szokásai? Gilicze Bálint az MTA-Debreceni Egyetem Lendület Funkcionális és Restaurációs Ökológiai Kutatócsoport vezetőjével, Török Péterrel beszélget az MTA Podcast új adásában A nyitószignál forrása: Freesound.org/X3nus – CC-BY 3.0 A lezáró blokk aláfestő zenéjének forrása: Soundcloud/PeriTune – CC-BY 3.0
-
MTA Podcast - beszélgetés Kontschán Jenővel, az ATK Növényvédelmi Intézet igazgatójával
22/10/2019 Duration: 01h05minTovábbi részletek, háttérinformáció az mta.hu-n megjelent kísérőcikkben: https://mta.hu/podcast/sosem-latott-jovevenyek-a-kertunkben-beszelgetes-kontschan-jenovel-az-atk-novenyvedelmi-intezet-igazgatojaval-110055 A nyitószignál forrása: Freesound.org/X3nus – CC-BY 3.0 Az átvezető zene forrása: Soundcloud/PeriTune – CC-BY 3.0
-
MTA Podcast - beszélgetés Barnaföldi Gergely Gábor részecskefizikussal
13/09/2019 Duration: 01h28minALICE csodaországban – beszélgetés Barnaföldi Gergely Gábor részecskefizikussal Hogyan segítheti az ősi univerzum megismerését egy huszonhét kilométer hosszú alagút? Mit látnak a kutatók, amikor két, közel fénysebességgel száguldó atommag egymásnak csapódik? Hogyan vizsgáljunk színes részecskéket grafikus kártyákkal? Gilicze Bálint az MTA Wigner Fizikai Kutatóközpont kutatójával, Barnaföldi Gergely Gáborral beszélget az MTA Podcast új adásában. További részletek, háttérinformáció az mta.hu-n megjelent kísérőcikkben: https://mta.hu/podcast/alice-csodaorszagban-beszelgetes-barnafoldi-gergely-gabor-reszecskefizikussal-109814 A nyitószignál forrása: Freesound.org/X3nus – CC-BY 3.0 Az átvezető zene forrása: Soundcloud/PeriTune – CC-BY 3.0
-
MTA Podcast - beszélgetés Szathmáry Eörs evolúcióbiológussal
09/09/2019 Duration: 49min„Nem jók a tudományos monokultúrák” – beszélgetés Szathmáry Eörs evolúcióbiológussal Az MTA Podcast új epizódjában az Ökológiai Kutatóközpont főigazgatójával Gilicze Bálint beszélgetett a vadonatúj Evolúciótudományi Intézetről, a szomszédban várakozó robotokról, a Földön kívüli élet esélyeiről és a közgondolkodás evolúciójáról. A szigorúan vett tudományos témákon túl szó esett arról is, milyen várakozásokkal tekint a régi-új intézményrendszerre, hogyan alakul át a kutatócsoportok szerepe, és milyen változásokat tartana üdvösnek az egyetemek világában. További részletek, háttérinformáció az mta.hu-n megjelent kísérőcikkben: https://mta.hu/podcast/nem-jok-a-tudomanyos-monokulturak-beszelgetes-szathmary-eors-evoluciobiologussal-109952 A nyitószignál forrása: Freesound.org/X3nus – CC-BY 3.0 Az átvezető zene forrása: Soundcloud/PeriTune – CC-BY 3.0
-
MTA podcast - interjú Varga Annával
01/03/2019 Duration: 01h08minEgy népmesei táj múltja és jövője – beszélgetés Varga Annával fáslegelőkről, pásztorokról és a hagyományos ökológiai tudásról Miért jó, ha terebélyes fák tarkítják a legelőt? Mit vesztett a vidék a termelőszövetkezetek megjelenésével? Újjáéledhet-e a pásztorvilág Magyarországon? Mit tanulhat az ökológus és a természetvédő a tájban élő, gazdálkodó embertől? Ilyen és ehhez hasonló kérdésekről beszélgetett Gilicze Bálint Varga Annával, az MTA Ökológiai Kutatóközpont Ökológiai és Botanikai Intézetének kutatójával az MTA Podcast új adásában. További részletek, háttérinformáció az mta.hu-n megjelent kísérőcikkben: https://mta.hu/podcast/egy-nepmesei-taj-multja-es-jovoje-beszelgetes-varga-annaval-faslegelokrol-pasztorokrol-es-a-hagyomanyos-okologiai-tudasrol-109430 A nyitószignál forrása: Freesound.org/X3nus – CC-BY 3.0 Az átvezető zene forrása: Soundcloud/PeriTune – CC-BY 3.0
-
MTA podcast - interjú Orbán Gergővel
07/02/2019 Duration: 45minBeszélgetés Orbán Gergővel, az MTA Wigner Fizikai Kutatóközpont munkatársával az agy matematikájáról egy frissen megjelent cikkük kapcsán További részletek, háttérinformáció az mta.hu-n megjelent kísérőcikkben: https://mta.hu/podcast/az-agy-matematikaja-beszelgetes-orban-gergovel-109352 A nyitószignál forrása: Freesound.org/X3nus – CC-BY 3.0 Az átvezető zene forrása: Soundcloud.com/PeriTune – CC-BY 3.0